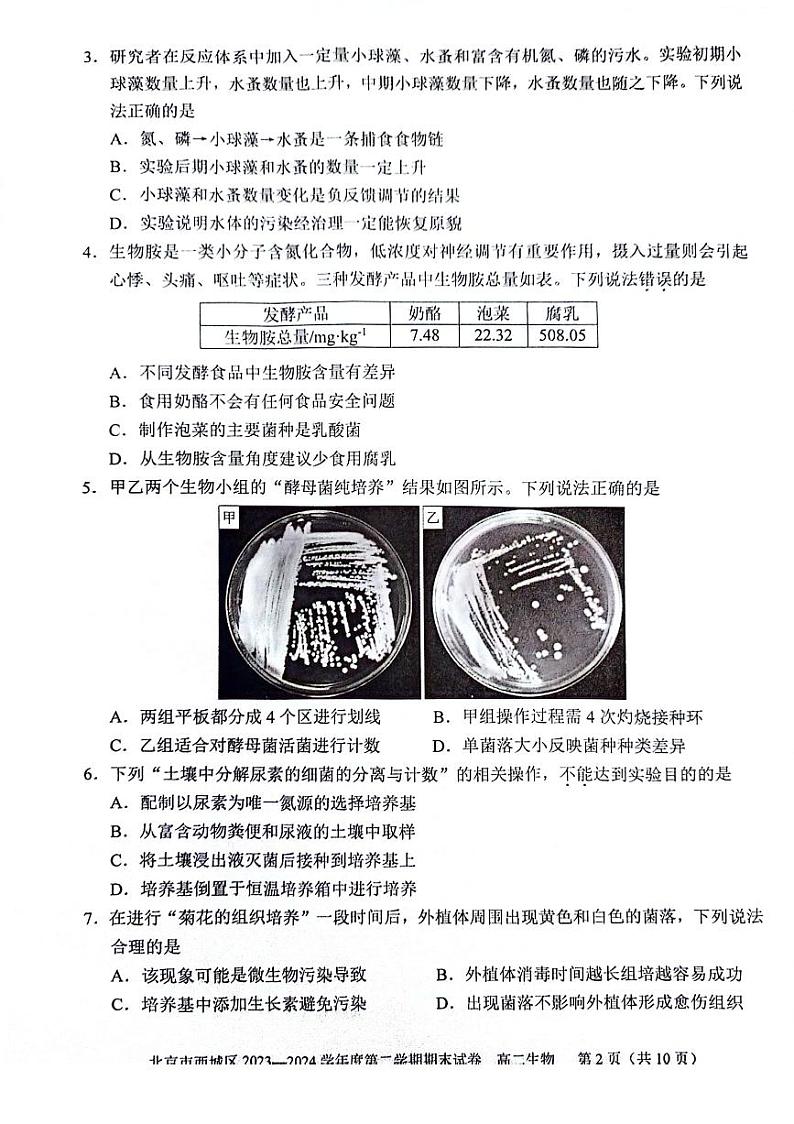
2024北京西城高二（下）期末生物试题及答案第2页

还剩9页未读,
继续阅读
2024北京西城高二(下)期末生物试题及答案
展开
这是一份2024北京西城高二(下)期末生物试题及答案,共12页。
相关试卷
2024北京西城高一(下)期末生物试题及答案:
这是一份2024北京西城高一(下)期末生物试题及答案,共12页。
北京西城区2023-2024高二下学期期末生物试卷及答案:
这是一份北京西城区2023-2024高二下学期期末生物试卷及答案,共12页。
2024北京西城高二(下)期末生物试题及答案:
这是一份2024北京西城高二(下)期末生物试题及答案,共12页。


![[生物][期末]2024北京西城高一(下)期末生物试卷](http://jx-previews-01.oss-cn-hangzhou.aliyuncs.com/3/11/15969142/0-1720714648406/0.jpg?x-oss-process=image/resize,w_202)





